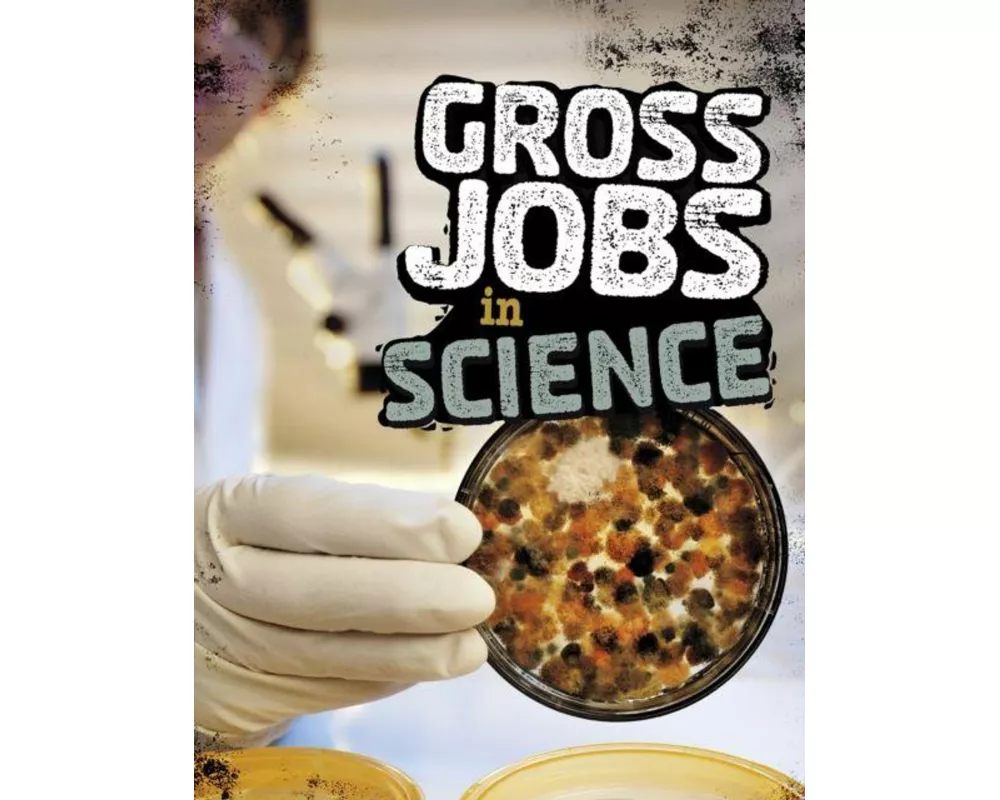
Gross Jobs in Science

Autor/-in: Nikki Bruno
Hier finden Sie zu den besten Preisen alle Bücher, eBooks und Hörbücher von Nikki Bruno.
Bestellungen bis 15:00 Uhr für Produkte auf Lager erhalten Sie - ohne Versandgebühr - am nächsten Werktag.
1
Meistgekauft
Erhältlich:
Nicht auf Lager
Gross Jobs Working With Food
CHF 24.79
2
Meistgekauft
Erhältlich:
Nicht auf Lager
Gross Jobs Working with Water and Sewers
CHF 24.79